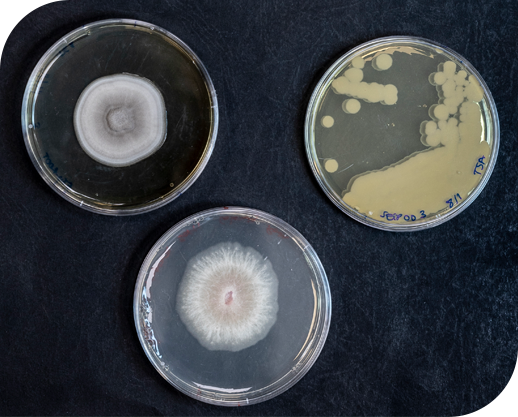
image

NATURAL TECHNOLOGY®
Natural Technology® modeli
Seipasa için Doğal Teknoloji, botanik ve mikrobiyolojik kökenli aktif maddelere uygulanan inovasyon ve araştırmaya dayalı tarım için etkili çözümler sunmak anlamına gelmektedir. Bu temelde şirket, biyoinsektisitlerin, biyofungusitlerin, biyostimülanların ve gübrelerin formülasyonu, geliştirilmesi ve üretimi için uyguladığı Natural Technology® modelini geliştirmiştir.
Seipasa'nın R+D+I Departmanı, en verimli, en etkili hammaddeleri belirlemek ve seçmek için çalışmalarında bu Natural Technology® modelini kullanmaktadır. Bu aktif maddeden en iyisini elde etmek ve dünyanın her yerinde ve her türlü uygulama koşulunda maksimum etkinliği garanti etmek için en son teknolojiyi kullanır. Natural Technology® modeli, Doğanın sağladığı hammaddelerle başlar, ancak daha sonra yirmi birinci yüzyılın öncü teknolojisini uygular.

Natural
Technology®
Technology®
Natural
Technology®'nin Önemli Noktaları